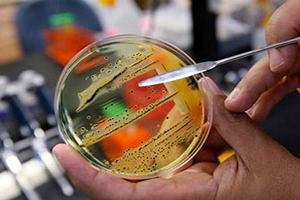
Заболеваемость сальмонеллезом в Германии неуклонно падает

|
Заболеваемость сальмонеллезом в Германии неуклонно падает
Сотрудники Федерального института по оценке рисков (BfR) провели оценку уровня заболеваемости инфекциями пищевого происхождения среди потребителей Германии и исследование мяса птицы на наличие пищевых патогенов. В результате было установлено, что число случаев сальмонеллеза последние годы неуклонно падает, в то время как количество заражений бактерией Campylobacter осталось на прежнем уровне.
В докладе говорится, что полностью предотвратить загрязнение тушек птицы опасными для здоровья людей патогенами пока не представляется возможным.
"Результаты нашего доклада показывают, что мы должны продолжать контролировать количество зоонозных заболеваний в птицеводстве и идентифицировать их при убое птицы", -- поясняет президент BfR, профессор Андреас Хенсель.
По его словам, теперь, на основании этого доклада, должны быть выработаны соответствующие меры для предотвращения и уменьшения зоонозных агентов на всех этапах производственного процесса.
Отчет BfR показал, что систематическое обследование родительских стад на предмет выявления заражения сальмонеллами привело к уменьшению количества инфицированных стад. Тем не менее, в настоящее время не существует никаких достаточно эффективных способов предотвращения передачи возбудителей через перья птиц и их желудочно-кишечный тракт.
В докладе сообщается, что другие патогены, такие как листерии и веротоксины кишечной палочки редко обнаруживаются в продуктах питания.
Листерией чаще всего оказываются загрязнены рыбные и полочне продукты. Этот патоген также иногда обнаруживают в овощах.
В целом доклад показывает, что Германия имеет действенные инструменты для эффективной борьбы с присутствием пищевых патогенов на всех этапах производства продукции и обеспечения высокого уровня пищевой безопасности.
Тем не менее, несмотря на все благие усилия производителей продуктов питания и государственных органов надзора, продукты питания по-прежнему будут содержать патогенные микроорганизмы. Поэтому, как подчеркивает BfR, высокую долю ответственности за обеспечение безопасности пищевой продукции несут сами потребители, которые должны тщательно соблюдать правила гигиены на кухне.
Источник:
http://foodcontrol.ru


